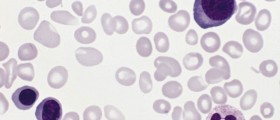

Does High Cholesterol Increase Your Risk Of Kidney Disease?
Sadly, chronic kidney disease does not have a permanent cure, but through the right course of treatment, a person can prevent the disease from getting worse by keeping it under control.

Can Soy Foods And Proteins Help Reduce Your High Cholesterol?
Soy is a very good source of protein, and one that’s particularly beneficial to people who have high cholesterol, because it doesn’t contain any bad fats or cholesterol.

5 Ways to Manage Cholesterol During Pregnancy
Managing high cholesterol during pregnancy can be a bit problematic, seeing as how you are not allowed to take any of the common meds that are normally prescribed to people who need to lower their cholesterol levels.

ICU Survivors Face High Risk Of Psychiatric Symptoms
A majority of patients who survived life-threatening illnesses and spent a substantial amount of time in an intensive care unit (ICU), seemed to have a high risk of developing anxiety, persistent depression and post-traumatic stress disorder (PTSD).

Before The Toothbrush: How Did Ancient Folks Keep Their Teeth Clean?
Oral hygiene as we know it is a relatively recent invention, so what did people people do before all this existed? Did they even practice oral hygiene? How effective was it? Read on.

Catch 22 For Diabetics Who Stop Smoking To Improve Their Health
Smoking increases the risk of type 2 diabetes; plus it’s important for diabetics to stop smoking if they want to regain their health. But a new study shows that during the first three to five years after diabetics who have quit, face greater health risks.

Singulair - prescription allergy and asthma medicine
Singulair is one of the most selling prescription allergy medicines used to treat perennial allergic rhinitis (usually triggered by indoor allergens ) in children as young as six months old and seasonal allergic rhinitis.

Polio (PPS): Symptoms & Treatment
Poliomyelitis, often called polio, is a viral paralytic disease. The cause of the disease is a virus called poliovirus which enters the body orally and infects the intestinal wall.
Myeloproliferative Disorders: Polycythemia vera
Polycythemia vera is a rare myeloproliferative disorder and it is estimated to occur in approximately 1 in 100,000 individuals.

How Are Sinusitis And Other Bacterial And Viral Respiratory Infections Connected To Asthma?
Patients with asthma know that bacterial and viral infections of the respiratory tract always worsen their asthma symptoms to some extent. Along with that, infections can induce asthma, both in children and in adults.